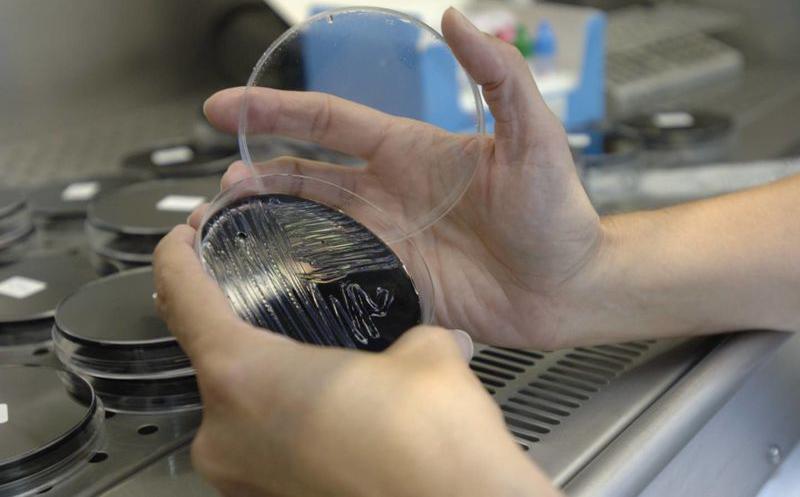
La Fiscalía remite a la provincial de Cáceres la petición de El Defensor del paciente de investigar los casos de legionela La Fiscalía remite a la provincial de Cáceres la petición de El Defensor del paciente de investigar los casos de legionela

LEGIONELA
01/09/2023 04:07
La Fiscalía remite a la provincial de Cáceres la petición de El Defensor del paciente de investigar los casos de legionela
hasta el momento, se ha registrado la muerte de un hombre de 86 años y hay siete pacientes ingresados con infección por legionela en Cáceres. Ayer ingresaba un varón de 74 años en el San Pedro de Alcántara.